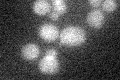
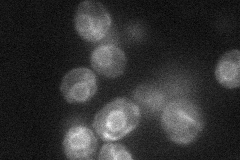
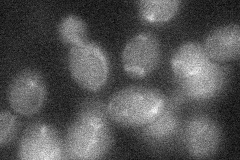

View description
Permease of basic amino acids in the vacuolar membrane
Localization:
Intensity:
Fold change:
Significance:
-
C’ GFP library in SD
below threshold15.08 -
N' NOP1pr-GFP in SD
ER30.0839 -
N' TEF2pr-mCherry in SD

cytosol,ER11.4762 -
N' NATIVEpr-GFP in SD

ER18.7667 -
N' TEF2pr-VC and Cyto-VN in SD
below threshold25.2474 -
C’ GFP library in SD+DTT

cytosol13.80.91No -
C’ GFP library in SD+H2O2

cytosol14.320.94No -
C’ GFP library in Starvation Media

cytosol15.291.01No -
C’ GFP library on the background of Pup2-DaMP

below threshold -
C’ GFP library on the background of CCT mutant

below threshold15.6781.03903No
